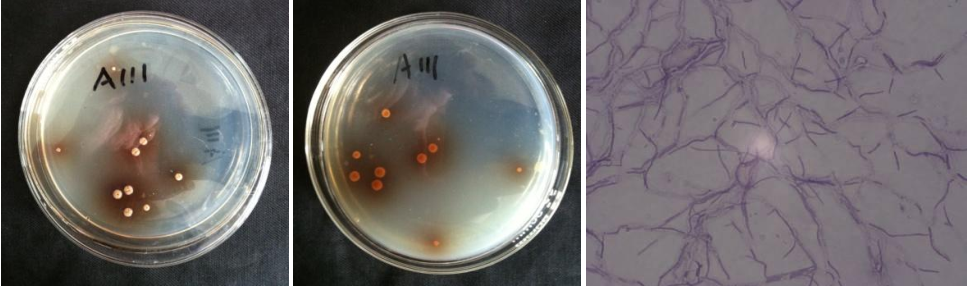

Loading...
| StrainNO | A111 |
| Classification | Streptacidiphilus |
| 16s rDNA sequence | TTTGATCCTGGCTCAGGACGAACGCTGGCGGCGTGCTTAACACATGCAAGTCGAACGGTGAAGCCCTTCGGGGTGGATCAGTGGC GAACGGGTGAGTAACACGTGGGTAATCTGCCCTGCATTCTGGGACAAGCCTTGGAAACGAGGTCTAATACCGGATACGACGCATC TCCGCATGGGGTGTGCGTGGAAAGCTCCGGCGATGCAGGATGAACCCGCGGCCTATCAGCTTGTTGGTGGGGTGATGGCCTACCA AGGCGACGACGGGTAGCCGGCCTGAGAGGGCGACCGGCCACACTGGGACTGAGACACGGCCCAGACTCCTACGGGAGGCAGCAGT GGGGAATATTGCACAATGGGCGAAAGCCTGATGCAGCGACGCCGCGTGAGGGATGACGGCCTTCGGGTTGTAAACCTCTTTCAGC AGGGAAGAAGCGCAAGTGACGGTACCTGCAGAAGAAGCACCGGCTAACTACGTGCCAGCAGCCGCGGTAATACGTAGGGTGCGAG CGTTGTCCGGAATTATTGGGCGTAAAGAGCTCGTAGGCGGCTTGTCGCGTCGGATGTGAAAGCCCGGGGCTTAACTCCGGGTCTG CATTCGATACGGGCAGGCTAGAGTGTGGTAGGGGAGATCGGAATTCCTGGTGTAGCGGTGAAATGCGCAGATATCAGGAGGAACA CCGGTGGCGAAGGCGGATCTCTGGGCCATTACTGACGCTGAGGAGCGAAAGCGTGGGGAGCGAACAGGATTAGATACCCTGGTAG TCCACGCCGTAAACGTTGGGAACTAGGTGTGGGTCACATTCCACGTGGTCCGCGCCGCAGCTAACGCATTAAGTTCCCCGCCTGG GGAGTACGGCCGCAAGGCTAAAACTCAAAGGAATTGACGGGGGCCCGCACAAGCAGCGGAGCATGTGGCTTAATTCGACGCAACG CGAAGAACCTTACCAAGGCTTGACATATACCGGAAACGTGCAGAGATGTACGCCCCCTTGTGGTCGGTATACAGGTGGTGCATGG TTGTCGTCAGCTCGTGTCGTGAGATGTTGGGTTAAGTCCCGCAACGAGCGCAACCCTCGTTCTGTGTTGCCAGCGGGTTATGCCG GGGACTCACAGGAGACTGCCGGGGTCAACTCGGAGGAAGGTGGGGACGACGTCAAATCATCATGCCCCTTATGTCTTGGGCTGCA CACGTGCTACAATGGCCGGTACAATGAGCTGCGATACCGCGAGGTGGAGCGAATCTCAAAAAGCCGGTCTCAGTTCGGATTGGGG TCTGCAACTCGACCCCATGAAGTCGGAGTTGCTAGTAATCGCAGATCAGCAGTGCTGCGGTGAATACGTTCCCGGGCCTTGTACA CACCGCCCGTCACGTCACGAAAGTCGGTAACACCCGAAGCCGGTGGCCTAACCCGTAAGGGACGCTAACCCGTAAGGGACG |
| Strain Morphology Photos | |
| Morphological Description | Mycelia branch;septum;spore filament short;straight;spore long round;old silk broken spore pile dirty white;back brownish red |